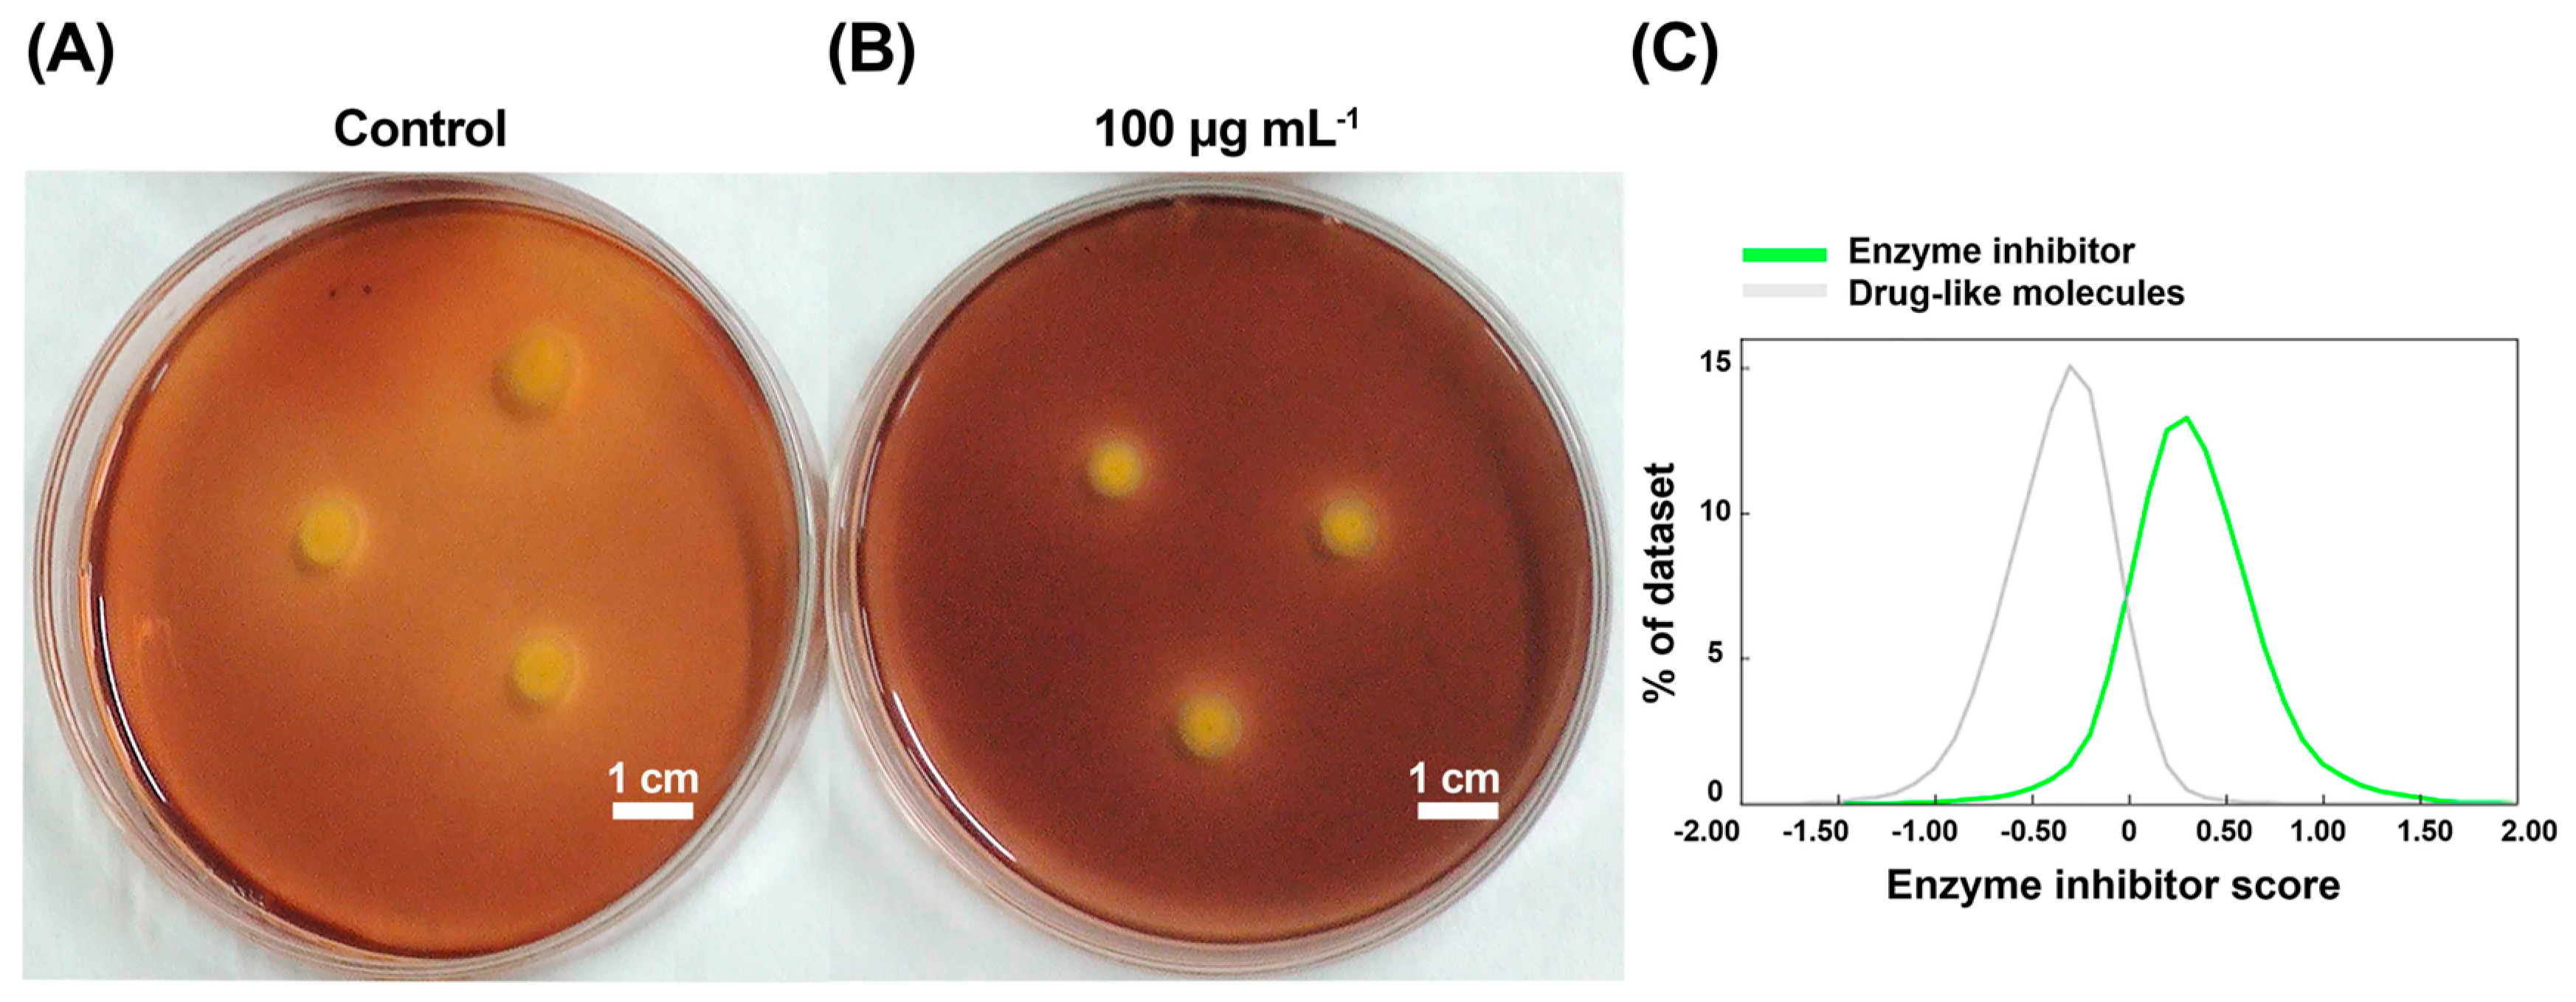
Molecules 29 04297 g005 Molecules 29 04297 g005

Resin Acid Copper Salt, an Interesting Chemical Pesticide, Controls Rice Bacterial Leaf Blight by Regulating Bacterial Biofilm, Motility, and Extracellular Enzymes
Abstract
1. Introduction
2. Results and Discussion
2.1. Anti-Xoo Potency Assessment of RACS
2.2. The Analysis of RACS against Xoo Biofilm Activity
2.3. The Analysis of Xoo Biofilm Formation Using Acridine Orange Staining
2.4. Inhibited Effects on Xoo Motility
2.5. The Inhibition Effect of Xoo Extracellular Hydrolases
2.6. The Control Effect and Phytotoxicity Evaluation of RACS against Xoo at a Dose of 200 μg mL−1 In Vivo
2.7. The Analysis of Absorption, Distribution, Metabolism, and Excretion Using the Software of ADMETlab 2.0
2.8. The Control Effect Evaluation of RACS Containing 0.3% Orange Peel Essential Oil against Xoo at a Dose of 200 μg mL−1 In Vivo
2.9. Influence of RACS on Bacterial Pathogenicity on Rice Plant at Control and 100 μg/mL
3. Materials and Methods
3.1. Instruments and Chemicals
3.2. The Potency Assessment of RACS against Xoo and Biofilm
3.3. Relative Expression Analysis of gumB Gene Coding EPS Using RT-qPCR
3.4. Fluorescent Staining Assay of Xoo Biofilm
3.5. Motility Assessment of RACS against Xoo
3.6. The Analysis of Xoo Extracellular Hydrolase Activity
3.7. The Curative Activity and Influence of RACS on Bacterial Pathogenicity against Xoo In Vivo
3.8. The Phytotoxicity Evaluation of RACS In Vivo
3.9. The Analysis of Absorption, Distribution, Metabolism, Excretion, and Toxicity (ADMET)
3.10. Statistical Analysis
4. Conclusions
Author Contributions
Funding
Institutional Review Board Statement
Informed Consent Statement
Data Availability Statement
Conflicts of Interest
References
- Feng, R.C.; Wang, H.C.; Liu, T.T.; Wang, F.; Cai, L.T.; Chen, X.J.; Zhang, S.B. Response of microbial communities in the phyllosphere ecosystem of tobacco exposed to the broad-spectrum copper hydroxide. Front. Microbiol. 2023, 14, 1229294. [Google Scholar] [CrossRef] [PubMed]
- Romanazzi, G.; Mancini, V.; Foglia, R.; Marcolini, D.; Kavari, M.; Piancatelli, S. Use of chitosan and other natural compounds alone or in different strategies with copper hydroxide for control of grapevine downy mildew. Plant Dis 2021, 105, 3261–3268. [Google Scholar] [CrossRef] [PubMed]
- Dong, H.Q.; Xiong, R.C.; Liang, Y.; Tang, G.; Yang, J.L.; Tang, J.Y.; Niu, J.F.; Gao, Y.H.; Zhou, Z.Y.; Cao, Y.S. Development of glycine-copper(II) hydroxide nanoparticles with improved biosafety for sustainable plant disease management. RSC Adv. 2020, 10, 21222–21227. [Google Scholar] [CrossRef] [PubMed]
- Cazorla, F.M.; Arrebola, E.; Olea, F.; Velasco, L.; Hermoso, J.M.; Pérez-García, A.; Torés, J.A.; Farré, J.M.; de Vicente, A. Field evaluation of treatments for the control of the bacterial apical necrosis of mango (Mangifera indica) caused by Pseudomonas syringae pv. syringae. Eur. J. Plant Pathol. 2006, 116, 279–288. [Google Scholar] [CrossRef]
- Gutiérrez-Barranquero, J.A.; Arrebola, E.; Bonilla, N.; Sarmiento, D.; Cazorla, F.M.; de Vicente, A. Environmentally friendly treatment alternatives to Bordeaux mixture for controlling bacterial apical necrosis (BAN) of mango. Plant Pathol. 2011, 61, 665–676. [Google Scholar] [CrossRef]
- Allen, W.R.; Dirk, V.A. The use of rapeseed oil to reduce premature defoliation in sweet cherry sprayed with bordeaux mixture for control of bacterial canker. Can. J. Plant. Sci. 1979, 59, 487–489. [Google Scholar] [CrossRef]
- Benmamoun, Z.; Wyhopen, T.; Li, Y.; Ducker, W.A. Mechanism and Efficacy of Cu2O-Treated Fabric. Antibiotics 2022, 11, 1633. [Google Scholar] [CrossRef]
- Carnegie, A.J.; Kathuria, A. Efficacy of cuprous oxide for control of dothistroma needle blight in Pinus radiata plantations in Australia. Aust. For. 2023, 85, 178–186. [Google Scholar] [CrossRef]
- Lee, Y.H.; Choi, C.W.; Kim, S.H.; Yun, J.G.; Chang, S.W.; Kim, Y.S.; Hong, J.K. Chemical pesticides and plant essential oils for disease control of tomato bacterial wilt. Plant Pathol. J. 2012, 28, 32–39. [Google Scholar] [CrossRef]
- Broniarek-Niemiec, A.; Børve, J.; Puławska, J. Control of bacterial canker in stone fruit trees by chemical and biological products. Agronomy 2023, 13, 1166. [Google Scholar] [CrossRef]
- Duin, I.M.; Forasteiro, T.A.; Rodrigues, V.H.S.; Balbi-Peña, M.I.; Júnior, R.P.L. In vitro sensitivity of Xanthomonas vasicola pv. vasculorum and the control of bacterial leaf streak of corn with copper oxychloride alone and in mixtures with mancozeb and fluxapyroxad. Eur. J. Plant Pathol. 2022, 164, 263–268. [Google Scholar]
- Cota-Ruiz, K.; Hernández-Viezcas, J.A.; Varela-Ramírez, A.; Valdés, C.; Núñez-Gastélum, J.A.; Martínez-Martínez, A.; Delgado-Rios, M.; Peralta-Videa, J.R.; Gardea-Torresdey, J.L. Toxicity of copper hydroxide nanoparticles, bulk copper hydroxide, and ionic copper to alfalfa plants: A spectroscopic and gene expression study. Environ. Pollut. 2018, 243, 703–712. [Google Scholar] [CrossRef] [PubMed]
- Lu, F.; Hu, P.P.; Lin, M.L.; Ye, X.; Chen, L.S.; Huang, Z.R. Photosynthetic Characteristics and Chloroplast Ultrastructure Responses of Citrus Leaves to Copper Toxicity Induced by Bordeaux Mixture in Greenhouse. Int. J. Mol. Sci. 2022, 23, 9835. [Google Scholar] [CrossRef]
- Chen, Y.F.; Luo, X.; Wang, Y.; Xing, Z.F.; Chen, J.X. Design and synthesis novel amide derivatives containing an 1,3,4-oxadiazole moiety as potential antibacterial agents. J. Heterocycl. Chem. 2022, 59, 1160–1168. [Google Scholar] [CrossRef]
- Dai, A.L.; Zheng, Z.G.; Huang, Y.Q.; Yu, L.J.; Wang, Z.C.; Wu, J. Hydrazone modification of non-food natural product sclareolide as potential agents for plant disease. Heliyon 2022, 8, e12391. [Google Scholar] [CrossRef]
- Zhang, H.; Zhang, R.S.; Qiao, J.Q.; Yu, J.J.; Qi, Z.Q.; Du, Y.; Yu, M.N.; Cao, H.J.; Song, T.Q.; Pan, X.Y.; et al. Optimization of Bacillus amyloliquefaciens Lx-11 suspoemulsion by response surface methodology to control rice bacterial blight. Biocontrol 2023, 68, 169–179. [Google Scholar] [CrossRef]
- Ren, G.G.; Ding, Z.H.; Pan, X.; Wei, G.H.; Wang, P.Y.; Liu, L.W. Evaluation of the abilities of three kinds of copper-based nanoparticles to control kiwifruit bacterial canker. Antibiotics 2022, 11, 891. [Google Scholar] [CrossRef]
- Wang, F.; Liu, H.W.; Zhang, L.; Liu, S.T.; Zhang, J.R.; Zhou, X.; Wang, P.Y.; Yang, S. Discovery of novel rost-4-ene derivatives as potential plant activators for preventing phytopathogenic bacterial infection: Design, synthesis and biological studies. Pest Manag. Sci. 2022, 78, 3404–3415. [Google Scholar] [CrossRef]
- Fei, Q.; Liu, C.Y.; Luo, Y.B.; Chen, H.J.; Ma, F.W.; Xu, S.; Wu, W.N. Rational design, synthesis, and antimicrobial evaluation of novel 1,2,4-trizaole-substituted 1,3,4-oxadiazole derivatives with a dual thioether moiety. Mol. Divers. 2024. [Google Scholar] [CrossRef]
- Liu, H.W.; Su, S.S.; Ma, S.Y.; Li, T.; Wang, F.; Ding, Y.; Liu, S.T.; Zhang, J.R.; Xiang, H.M.; Zhou, X.; et al. Discovery and structural optimization of 1,2,3,4-tetrahydro-β-carbolines as novel reactive oxygen species inducers for controlling intractable plant bacterial diseases. J. Agric. Food Chem. 2023, 71, 11035–11047. [Google Scholar] [CrossRef]
- Zhang, M.M.; Han, S.; Niu, X.H.; Li, H.X.; Zhang, D.Y.; Fan, H.Y.; Liu, X.Y.; Wang, K.J. PPy and CQDs-doped novel CuO nanocomposites for enhanced antibacterial activity against drug-resistant bacteria. ChemistrySelect 2022, 7, e202203636. [Google Scholar] [CrossRef]
- Madhu Sekhar, M.; Nagarjuna, U.; Padmavathi, V.; Padmaja, A.; Reddy, N.V.; Vijaya, T. Synthesis and antimicrobial activity of pyrimidinyl 1,3,4-oxadiazoles, 1,3,4-thiadiazoles and 1,2,4-triazoles. Eur. J. Med. Chem. 2018, 145, 1–10. [Google Scholar] [CrossRef] [PubMed]
- Yao, T.S.; Zhou, C.Y.; Hu, J.H.; Lei, H.D.; Ran, C.; Li, H.J.; Liu, H.Q.; Xiao, T. Screening of control bactericides of Xanthomonas axonopodis pv. citri. J. Yunnan Agric. Univ. 2011, 26, 30–33. [Google Scholar]
- Favaro, M.A.; Roeschlin, R.A.; Ribero, G.G.; Maumary, R.L.; Fernandez, L.N.; Lutz, A.; Sillon, M.; Rista, L.M.; Marano, M.R.; Gariglio, N.F. Relationships between copper content in orange leaves, bacterial biofilm formation and citrus canker disease control after different copper treatments. Crop Prot. 2017, 92, 182–189. [Google Scholar] [CrossRef]
- Ito, Y.; Ito, T.; Yamashiro, K.; Mineshiba, F.; Hirai, K.; Omori, K.; Yamamoto, T.; Takashiba, S. Antimicrobial and antibiofilm effects of abietic acid on cariogenic Streptococcus mutans. Odontology 2020, 108, 57–65. [Google Scholar] [CrossRef]
- Dzięgielewska, M.; Bartoszewicz, M.; Książczyk, M.; Dudek, B.; Brożyna, M.; Szymczyk-Ziółkowska, P.; Gruber, P.; Pawlak, J.; Kozłowska, W.; Zielińska, S.; et al. Abietic acid as a novel agent against ocular biofilms: An in vitro and preliminary in vivo investigation. Int. J. Mol. Sci. 2024, 25, 1528. [Google Scholar] [CrossRef]
- Buch, P.J.; Chai, Y.; Goluch, E.D. Treating polymicrobial infections in chronic diabetic wounds. Clin. Microbiol. Rev. 2019, 32, e00091-18. [Google Scholar] [CrossRef]
- Baker, P.; Hill, P.J.; Snarr, B.D.; Alnabelseya, N.; Pestrak, M.J.; Lee, M.J.; Jennings, L.K.; Tam, J.; Melnyk, R.A.; Parsek, M.R.; et al. Exopolysaccharide biosynthetic glycoside hydrolases can be utilized to disrupt and prevent Pseudomonas aeruginosa biofilms. Adv. Sci. 2016, 2, e1501632. [Google Scholar] [CrossRef]
- Heo, K.; Park, Y.H.; Lee, K.A.; Kim, J.; Ham, H.I.; Kim, B.G.; Lee, W.J.; Seok, Y.J. Sugar-mediated regulation of a c-di-GMP phosphodiesterase in Vibrio cholerae. Nat. Commun. 2019, 10, 5358. [Google Scholar] [CrossRef]
- El-Messery, S.M.; Habib, E.-S.E.; Al-Rashood, S.T.A.; Hassan, G.S. Synthesis, antimicrobial, anti-biofilm evaluation, and molecular modelling study of new chalcone linked amines derivatives. J. Enzyme Inhib. Med. Chem. 2018, 33, 818–832. [Google Scholar] [CrossRef]
- Rajput, A.; Thakur, A.; Sharma, S.; Kumar, M. aBiofilm: A resource of anti-biofilm agents and their potential implications in targeting antibiotic drug resistance. Nucleic Acids Res. 2018, 46, D894–D900. [Google Scholar] [CrossRef] [PubMed]
- Hussain, A.; Alajmi, M.F.; Khan, M.A.; Pervez, S.A.; Ahmed, F.; Amir, S.; Husain, F.M.; Khan, M.S.; Shaik, G.M.; Hassan, I.; et al. Biosynthesized silver nanoparticle (AgNP) from pandanus odorifer leaf extract exhibits anti-metastasis and anti-biofilm potentials. Front. Microbiol. 2019, 10, 8. [Google Scholar] [CrossRef] [PubMed]
- Peeters, N.; Guidot, A.; Vailleau, F.; Valls, M. Ralstonia solanacearum, a widespread bacterial plant pathogen in the post-genomic era. Mol. Plant Pathol 2013, 14, 651–662. [Google Scholar] [CrossRef] [PubMed]
- Haque, M.M.; Kabir, M.S.; Aini, L.Q.; Hirata, H.; Tsuyumu, S. SlyA, a MarR family transcriptional regulator, is essential for virulence in Dickeya dadantii 3937. J. Bacteriol. 2009, 191, 5409–5418. [Google Scholar] [CrossRef] [PubMed]
- Liang, X.Y.; Yu, X.Y.; Dong, W.X.; Guo, S.J.; Xu, S.; Wang, J.X.; Zhou, M.G. Two thiadiazole compounds promote rice defence against Xanthomonas oryzae pv. oryzae by suppressing the bacterium’s production of extracellular polysaccharides. Mol. Plant Pathol 2015, 16, 882–892. [Google Scholar]
- Yu, X.Y.; Liang, X.Y.; Liu, K.X.; Dong, W.X.; Wang, J.X.; Zhou, M.G. The thiG gene is required for full virulence of Xanthomonas oryzae pv. oryzae by preventing cell aggregation. PLoS ONE 2015, 10, e0134237. [Google Scholar]
- Qi, P.Y.; Wang, N.; Zhang, T.H.; Feng, Y.M.; Zhou, X.; Zeng, D.; Meng, J.; Liu, L.W.; Jin, L.H.; Yang, S. Anti-virulence strategy of novel dehydroabietic acid derivatives: Design, synthesis, and antibacterial evaluation. Int. J. Mol. Sci. 2023, 24, 2897. [Google Scholar] [CrossRef]
- Duncan, B.; Li, X.N.; Landis, R.F.; Kim, S.T.; Gupta, A.; Wang, L.S.; Ramanathan, R.; Tang, R.; Boerth, J.A.; Rotello, V.M. Nanoparticle-stabilized capsules for the treatment of bacterial biofilms. ACS Nano 2015, 9, 7775–7782. [Google Scholar] [CrossRef]
- Yang, L.; Li, S.L.; Qin, X.Y.; Jiang, G.F.; Chen, J.N.; Li, B.D.; Yao, X.; Liang, P.B.; Zhang, Y.; Ding, W. Exposure to umbelliferone reduces Ralstonia solanacearum biofilm formation, transcription of type III secretion system regulators and effectors and virulence on tobacco. Front. Microbiol. 2017, 8, 1234. [Google Scholar] [CrossRef]
- Chae, K.; Jang, W.Y.; Park, K.; Lee, J.; Kim, H.; Lee, K.; Lee, C.K.; Lee, Y.; Lee, S.H.; Seo, J. Antibacterial infection and immune-evasive coating for orthopedic implants. Sci. Adv. 2020, 6, eabb0025. [Google Scholar] [CrossRef]
- Dziewit, L.; Bartosik, D. Plasmids of psychrophilic and psychrotolerant bacteria and their role in adaptation to cold environments. Front. Microbiol. 2014, 5, 596. [Google Scholar] [CrossRef] [PubMed]
- Yao, J.; Allen, C. Chemotaxis is required for virulence and competitive fitness of the bacterial wilt pathogen Ralstonia solanacearum. J Bacteriol 2006, 188, 3697–3708. [Google Scholar] [CrossRef] [PubMed]
- Liu, J.; Dong, Y.H.; Wang, N.N.; Li, S.G.; Yang, Y.; Wang, Y.; Awan, F.; Lu, C.P.; Liu, Y.J. Tetrahymena thermophila predation enhances environmental adaptation of the carp pathogenic strain Aeromonas hydrophila NJ-35. Front. Cell. Infect. Microbiol. 2018, 8, 76. [Google Scholar] [CrossRef]
- Ringgaard, S.; Hubbard, T.; Mandlik, A.; Davis, B.M.; Waldor, M.K. RpoS and quorum sensing control expression and polar localization of Vibrio cholerae chemotaxis cluster III proteins in vitro and in vivo. Mol. Microbiol. 2015, 97, 660–675. [Google Scholar] [CrossRef]
- Rodríguez-Rojas, A.; Kim, J.J.; Johnston, P.R.; Makarova, O.; Eravci, M.; Weise, C.; Hengge, R.; Rolff, J. Non-lethal exposure to H2O2 boosts bacterial survival and evolvability against oxidative stress. PLoS Genet. 2020, 16, e1008649. [Google Scholar] [CrossRef]
- Thota, S.S.; Chubiz, L.M. Multidrug resistance regulators MarA, SoxS, Rob, and RamA repress flagellar gene expression and motility in Salmonella enterica serovar typhimurium. J. Bacteriol. 2019, 201, e00385-19. [Google Scholar] [CrossRef] [PubMed]
- Yeung, A.T.Y.; Torfs, E.C.W.; Jamshidi, F.; Bains, M.; Wiegand, I.; Hancock, R.E.W.; Overhage, J. Swarming of Pseudomonas aeruginosaIs controlled by a broad spectrum of transcriptional regulators, Including MetR. J. Bacteriol. 2009, 191, 5592–5602. [Google Scholar] [CrossRef]
- Kurre, R.; Maier, B. Oxygen depletion triggers switching between discrete speed modes of gonococcal type IV Pili. Biophys. J. 2012, 102, 2556–2563. [Google Scholar] [CrossRef][Green Version]
- Drabinska, J.; Ziecina, M.; Modzelan, M.; Jagura-Burdzy, G.; Kraszewska, E. Individual Nudix hydrolases affect diverse features of Pseudomonas aeruginosa. MicrobiologyOpen 2020, 9, e1052. [Google Scholar] [CrossRef]
- Abramovitch, R.B.; Anderson, J.C.; Martin, G.B. Bacterial elicitation and evasion of plant innate immunity. Nat. Rev. Mol. Cell Biol. 2006, 7, 601–611. [Google Scholar] [CrossRef]
- Gao, S.G.; Li, Y.Q.; Gao, J.X.; Suo, Y.J.; Fu, K.H.; Li, Y.Y.; Chen, J. Genome sequence and virulence variation-related transcriptome profiles of Curvularia lunata,an important maize pathogenic fungus. BMC Genom. 2014, 15, 627. [Google Scholar] [CrossRef] [PubMed]
- Huang, Y.D.; Li, L.; Smith, K.P.; Muehlbauer, G.J. Differential transcriptomic responses to Fusarium graminearum infection in two barley quantitative trait loci associated with Fusarium head blight resistance. BMC Genom. 2016, 17, 387. [Google Scholar] [CrossRef] [PubMed]
- Chen, S.L.; Wilson, D.B. Proteomic and transcriptomic analysis of extracellular proteins and mRNA levels in Thermobifida fusca grown on cellobiose and glucose. J. Bacteriol. 2007, 189, 6260–6265. [Google Scholar] [CrossRef]
- Li, L.; Yuan, L.F.; Shi, Y.X.; Xie, X.W.; Chai, A.L.; Wang, Q.; Li, B.J. Comparative genomic analysis of Pectobacterium carotovorum subsp. brasiliense SX309 provides novel insights into its genetic and phenotypic features. BMC Genom. 2019, 20, 486. [Google Scholar]
- Price, C.; Jones, S.; Mihelcic, M.; Santic, M.; Kwaik, Y.A. Paradoxical pro-inflammatory responses by human macrophages to an amoebae host-adapted Legionella effector. Cell Host Microbe 2020, 27, 571–584. [Google Scholar] [CrossRef]
- Yang, Y.K.; Yang, X.F.; Dong, Y.J.; Qiu, D.W. The Botrytis cinerea xylanase BcXyl1 modulates plant immunity. Front. Microbiol. 2018, 9, 2535. [Google Scholar] [CrossRef] [PubMed]
- da Silva, L.B.; Menezes, M.C.; Kitano, E.S.; Oliveira, A.K.; Abreu, A.G.; Souza, G.O.; Heinemann, M.B.; Isaac, L.; Fraga, T.R.; Serrano, S.M.T.; et al. Leptospira interrogans secreted proteases degrade extracellular matrix and plasma proteins from the host. Front. Cell. Infect. Microbiol. 2018, 8, 92. [Google Scholar] [CrossRef]
- Michel, G.P.; Durand, E.; Filloux, A. XphA/XqhA, a novel GspCD subunit for Type II secretion in Pseudomonas aeruginosa. J. Bacteriol. 2007, 189, 3776–3783. [Google Scholar] [CrossRef]
- Zhang, Z.C.; Zhao, M.; Xu, L.D.; Niu, X.N.; Qin, H.P.; Li, Y.M.; Li, M.L.; Jiang, Z.W.; Yang, X.; Huang, G.H.; et al. Genome-wide screening for novel candidate virulence related response regulator genes in Xanthomonas oryzae pv. oryzicola. Front. Microbiol. 2018, 9, 1789. [Google Scholar] [CrossRef]
- Liu, S.S.; Zeng, D.; Zhang, T.H.; Hu, J.H.; Yang, B.X.; Yang, J.; Zhou, X.; Wang, P.Y.; Liu, L.W.; Wu, Z.B.; et al. Novel spiro[chromanone-2,4′-piperidine]-4-one derivatives as potential inhibitors of fatty acid synthesis in pathogens: Design, synthesis, and biological evaluation. Eur. J. Med. Chem. 2023, 250, 115215. [Google Scholar] [CrossRef]
- Qi, P.Y.; Zhang, T.H.; Yang, Y.K.; Liang, H.; Feng, Y.M.; Wang, N.; Ding, Z.H.; Xiang, H.M.; Zhou, X.; Liu, L.W.; et al. Beyond the β-amino alcohols framework: Identification of novel β-hydroxy pyridinium salt-decorated pterostilbene derivatives as bacterial virulence factor inhibitors. Pest. Manag. Sci. 2024, 80, 4098–4109. [Google Scholar] [CrossRef] [PubMed]
- Zhang, J.J.; Feng, Y.M.; Zhang, J.R.; Xiao, W.L.; Liu, S.S.; Zhou, X.; Zhang, H.; Wang, P.Y.; Liu, L.W.; Yang, S. Resistance-driven innovations in the discovery of bactericides: Novel triclosan derivatives decorating isopropanolamine moiety as promising anti-biofilm agents against destructive plant bacterial diseases. Pest Manag. Sci. 2023, 79, 2443–2455. [Google Scholar] [CrossRef] [PubMed]
- Yang, J.; Ye, H.J.; Xiang, H.M.; Zhou, X.; Wang, P.Y.; Liu, S.S.; Yang, B.X.; Yang, H.B.; Liu, L.W.; Yang, S. Photo-stimuli smart supramolecular self-assembly of azobenzene/β-cyclodextrin inclusion complex for controlling plant bacterial diseases. Adv. Funct. Mater. 2023, 33, 202303206. [Google Scholar] [CrossRef]
- Qi, P.Y.; Zhang, T.H.; Feng, Y.M.; Wang, M.W.; Shao, W.B.; Zeng, D.; Jin, L.H.; Wang, P.Y.; Zhou, X.; Yang, S. Exploring an innovative strategy for suppressing bacterial plant disease: Excavated novel isopropanolamine-tailored pterostilbene derivatives as potential antibiofilm agents. J. Agric. Food Chem. 2022, 70, 4899–4911. [Google Scholar] [CrossRef]
- Zhou, X.; Fu, Y.H.; Zou, Y.Y.; Meng, J.; Ou-Yang, G.P.; Ge, Q.S.; Wang, Z.C. Discovery of simple diacylhydrazine-functionalized cinnamic acid derivatives as potential microtubule stabilizers. Int. J. Mol. Sci. 2022, 23, 12365. [Google Scholar] [CrossRef]

| Xoo | ||||||
|---|---|---|---|---|---|---|
| Compound | 500 (µg mL−1) | 100 (µg mL−1) | 50 (µg mL−1) | Regression Equation | EC50 (µg/mL) a | R2 |
| RACS | 100 ± 2.31 | 64.3 ± 1.52 | 50.2 ± 1.63 | y = 1.15x + 3.06 | 50.0 ± 4.43 | 0.9996 |
| Treatment | Curative Activity | ||
|---|---|---|---|
| Morbidity (%) | Disease Index (%) | Control Efficiency (%) b | |
| RACS | 100 | 56.7 | 38.5 |
| Control a | 100 | 92.2 | / |
| Treatment | Curative Activity | ||
|---|---|---|---|
| Morbidity (%) | Disease Index (%) | Control Efficiency (%) b | |
| RACS + 0.3% OPEO | 100 | 51.2 | 45.0 |
| Water a | 100 | 93.1 | / |
Disclaimer/Publisher’s Note: The statements, opinions and data contained in all publications are solely those of the individual author(s) and contributor(s) and not of MDPI and/or the editor(s). MDPI and/or the editor(s) disclaim responsibility for any injury to people or property resulting from any ideas, methods, instructions or products referred to in the content. |
© 2024 by the authors. Licensee MDPI, Basel, Switzerland. This article is an open access article distributed under the terms and conditions of the Creative Commons Attribution (CC BY) license (https://creativecommons.org/licenses/by/4.0/).
Share and Cite
Shi, L.; Zhou, X.; Qi, P. Resin Acid Copper Salt, an Interesting Chemical Pesticide, Controls Rice Bacterial Leaf Blight by Regulating Bacterial Biofilm, Motility, and Extracellular Enzymes. Molecules 2024, 29, 4297. https://doi.org/10.3390/molecules29184297
Shi L, Zhou X, Qi P. Resin Acid Copper Salt, an Interesting Chemical Pesticide, Controls Rice Bacterial Leaf Blight by Regulating Bacterial Biofilm, Motility, and Extracellular Enzymes. Molecules. 2024; 29(18):4297. https://doi.org/10.3390/molecules29184297
Chicago/Turabian StyleShi, Lihong, Xiang Zhou, and Puying Qi. 2024. "Resin Acid Copper Salt, an Interesting Chemical Pesticide, Controls Rice Bacterial Leaf Blight by Regulating Bacterial Biofilm, Motility, and Extracellular Enzymes" Molecules 29, no. 18: 4297. https://doi.org/10.3390/molecules29184297
APA StyleShi, L., Zhou, X., & Qi, P. (2024). Resin Acid Copper Salt, an Interesting Chemical Pesticide, Controls Rice Bacterial Leaf Blight by Regulating Bacterial Biofilm, Motility, and Extracellular Enzymes. Molecules, 29(18), 4297. https://doi.org/10.3390/molecules29184297






